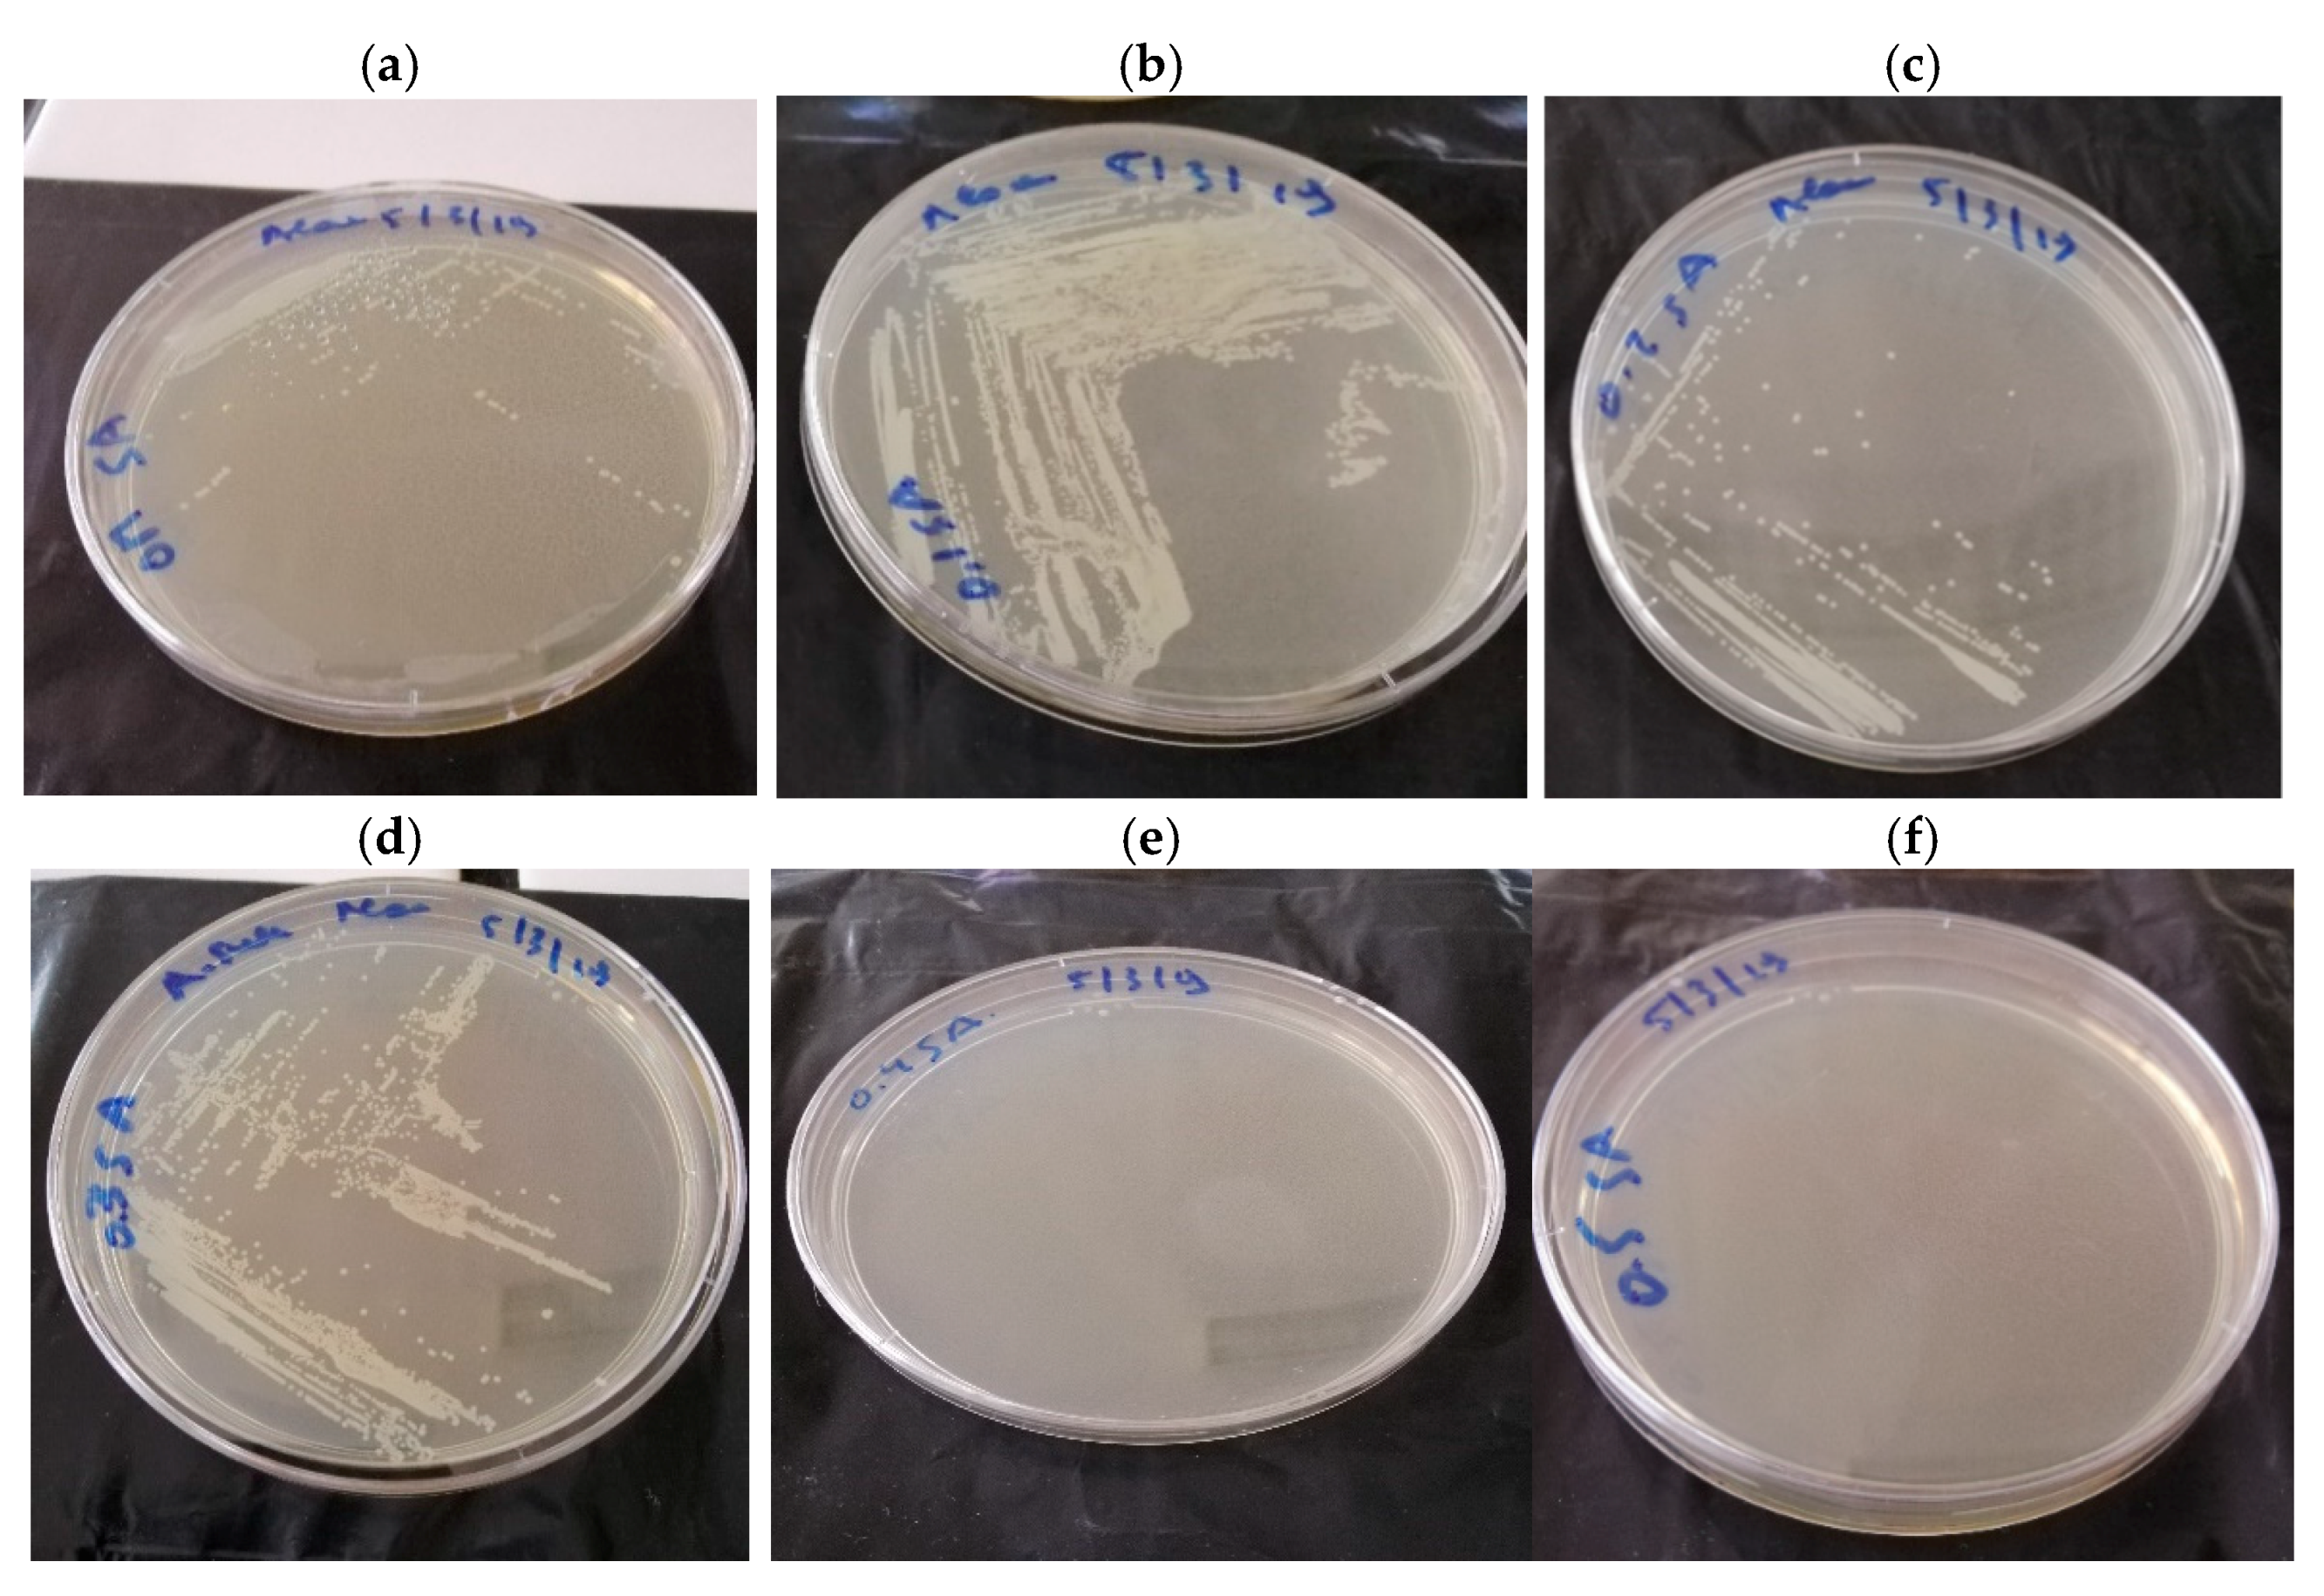
Applmicrobiol 01 00022 g008 Applmicrobiol 01 00022 g008

Well Knowledge of the Physiology of Actinobacillus succinogenes to Improve Succinic Acid Production
Abstract
1. Introduction
2. Material and Methods
2.1. Chemical and Gas
2.2. Microorganism and Inoculums Preparation
2.3. Fermentation Media and Experimental Design
2.4. Fermentation Conditions and Sampling
2.5. Analytical Methods and Data Analysis
3. Results and Discussion
3.1. Results from 250 mL Shake Flask Reactors Using Glucose as Carbon Source in Micro-Aerobic and Anaerobic Conditions
3.2. Results from 250 mL Anaerobic Bottles Using Sole and Mixed Sugars as Carbon Source in Anaerobic Conditions
3.3. Improvement of Succinic Acid Production by the Addition of Mediator in 250 mL Anaerobic Bottles
3.4. Conversion of FA into Succinic Acid in Actinobacillus succinogenes
3.5. Mass Balance Analysis (MBA)
3.6. Batch Fermentation Realized in 1 L Reactors
3.7. Fermentation in the Bench-Top Fermenters (B-TFs)
3.7.1. pH Regulation
3.7.2. Fermentation Studies in Different Sizes of Bioreactors
3.8. Effect of SA on Bacterial Growth
4. Conclusions
Author Contributions
Funding
Institutional Review Board Statement
Data Availability Statement
Acknowledgments
Conflicts of Interest
Consent to Participate
Appendix A
| Glycolysis | Pentose phosphate |
| TCA Cycle | |
| Fructose catabolism | |
| Transhydrogenation | |
| Biomass formation equation | By-products |
| Not Available | Not detetcted |
References
- Kohli, K.; Prajapati, R.; Sharma, B.K. Bio-based chemicals from renewable biomass for integrated biorefineries. Energies 2019, 12, 233. [Google Scholar] [CrossRef]
- Ventorino, V.; Robertiello, A.; Cimini, D.; Argenzio, O.; Schiraldi, C.; Montella, S.; Faraco, V.; Ambrosanio, A.; Viscardi, S.; Pepe, O. Bio-based succinate production from Arundo donax hydrolysate with the new natural succinic acid-producing strain Basfia succiniciproducens BPP7. Bioenergy Res. 2017, 10, 488–498. [Google Scholar] [CrossRef]
- Carvalho, M.; Roca, C.; Reis, M.A. Improving succinic acid production by Actinobacillus succinogenes from raw industrial carob pods. Bioresour. Technol. 2016, 218, 491–497. [Google Scholar] [CrossRef] [PubMed]
- Ferone, M.; Raganati, F.; Olivieri, G.; Salatino, P.; Marzocchella, A. Continuous succinic acid fermentation by Actinobacillus succinogenes: Assessment of growth and succinic acid production kinetics. Appl. Biochem. Biotechnol. 2018, 187, 782–799. [Google Scholar] [CrossRef]
- Pinkos, R.; Rittinger, S.; Nuebling, C.; Abillard, O. Method for Hydrogenating Carboxylic Acids in order to Form Alcohols. U.S. Patent No. 10,450,252, 22 October 2019. [Google Scholar]
- Marion, P.; Bernela, B.; Piccirilli, A.; Estrine, B.; Patouillard, N.; Guilbot, J.; Jérôme, F. Sustainable chemistry: How to produce better and more from less? Green Chem. 2017, 19, 4973–4989. [Google Scholar] [CrossRef]
- Kircher, M. Bioeconomy: Markets, implications, and investment opportunities. Economies 2019, 7, 73. [Google Scholar] [CrossRef]
- Julio, R.; Albet, J.; Vialle, C.; Vaca-Garcia, C.; Sablayrolles, C. Sustainable design of biorefinery processes: Existing practices and new methodology. Biofuels Bioprod. Biorefining 2017, 11, 373–395. [Google Scholar] [CrossRef]
- Salma, A.; Djelal, H.; Abdallah, R.; Fourcade, F.; Amrane, A. Platform molecule from sustainable raw materials; case study succinic acid. Braz. J. Chem. Eng. 2021, 38, 215–239. [Google Scholar] [CrossRef]
- Srivastava, R.K. Bio-energy production by contribution of effective and suitable microbial system. Mater. Sci. Energy Technol. 2019, 2, 308–318. [Google Scholar] [CrossRef]
- Lee, S.Y.; Kim, H.U.; Chae, T.U.; Cho, J.S.; Kim, J.W.; Shin, J.H.; Kim, D.I.; Ko, Y.-S.; Jang, W.D.; Jang, Y.-S. A comprehensive metabolic map for production of bio-based chemicals. Nat. Catal. 2019, 2, 18–33. [Google Scholar] [CrossRef]
- Pinazo, J.M.; Domine, M.E.; Parvulescu, V.; Petru, F. Sustainability metrics for succinic acid production: A comparison between biomass-based and petrochemical routes. Catal. Today 2015, 239, 17–24. [Google Scholar] [CrossRef]
- Brar, S.K.; Sarma, S.J.; Pakshirajan, K. Platform Chemical Biorefinery: Future Green Chemistry; Elsevier: Amsterdam, The Netherlands, 2016. [Google Scholar]
- Yamauchi, Y.; Hirasawa, T.; Nishii, M.; Furusawa, C.; Shimizu, H. Enhanced acetic acid and succinic acid production under microaerobic conditions by Corynebacterium glutamicum harboring Escherichia coli transhydrogenase gene pntAB. J. Gen. Appl. Microbiol. 2014, 60, 112–118. [Google Scholar] [CrossRef] [PubMed]
- Amulya, K.; Mohan, S.V. Fixation of CO2, electron donor and redox microenvironment regulate succinic acid production in Citrobacter amalonaticus. Sci. Total Environ. 2019, 695, 133838. [Google Scholar] [CrossRef]
- Almqvist, H.; Pateraki, C.; Alexandri, M.; Koutinas, A.; Liden, G. Succinic acid production by Actinobacillus succinogenes from batch fermentation of mixed sugars. J. Ind. Microbiol. Biotechnol. 2016, 43, 1117–1130. [Google Scholar] [CrossRef] [PubMed]
- Ferone, M.; Raganati, F.; Ercole, A.; Olivieri, G.; Salatino, P.; Marzocchella, A. Continuous succinic acid fermentation by Actinobacillus succinogenes in a packed-bed biofilm reactor. Biotechnol. Biofuels 2018, 11, 1–11. [Google Scholar] [CrossRef]
- Nghiem, N.P.; Kleff, S.; Schwegmann, S. Succinic acid: Technology development and commercialization. Fermentation 2017, 3, 26. [Google Scholar] [CrossRef]
- Herselman, J. Rate and Yield Dependency of Actinobacillus succinogenes on Dissolved CO2 Concentration. Ph.D. Thesis, University of Pretoria, Pretoria, South Africa, 2017. [Google Scholar]
- Cheng, K.-K.; Wang, G.-Y.; Zeng, J.; Zhang, J.-A. Improved succinate production by metabolic engineering. BioMed Res. Int. 2013, 2013. [Google Scholar] [CrossRef] [PubMed]
- Bernhard, S.A.; Tompa, P. The mechanism of succinate or fumarate transfer in the tricarboxylic acid cycle allows molecular rotation of the intermediate. Arch. Biochem. Biophys. 1990, 276, 191–198. [Google Scholar] [CrossRef]
- Li, Q.; Xing, J. Production of 1,4-diacids (succinic, fumaric, and malic) from biomass. In Production of Platform Chemicals from Sustainable Resources; Fang, Z., Smith, R.L., Jr., Qi, X., Eds.; Springer: Singapore, 2017; pp. 231–262. [Google Scholar]
- Zheng, P.; Dong, J.-J.; Sun, Z.-H.; Ni, Y.; Fang, L. Fermentative production of succinic acid from straw hydrolysate by Actinobacillus succinogenes. Bioresour. Technol. 2009, 100, 2425–2429. [Google Scholar] [CrossRef]
- Carvalho, M.; Roca, C.; Reis, M.A. Carob pod water extracts as feedstock for succinic acid production by Actinobacillus succinogenes 130Z. Bioresour. Technol. 2014, 170, 491–498. [Google Scholar] [CrossRef]
- Wan, C.; Li, Y.; Shahbazi, G.; Xiu, S. Succinic acid production from cheese whey using Actinobacillus succinogenes 130 Z. Appl. Biochem. Biotechnol. 2008, 145, 111–119. [Google Scholar] [CrossRef]
- Bukhari, N.A.; Loh, S.K.; Nasrin, A.B.; Luthfi, A.A.I.; Harun, S.; Abdul, P.M.; Jahim, J.M. Compatibility of utilising nitrogen-rich oil palm trunk sap for succinic acid fermentation by Actinobacillus succinogenes 130Z. Bioresour. Technol. 2019, 293, 122085. [Google Scholar] [CrossRef] [PubMed]
- Djelal, H.; Amrane, A.; Lahrer, F.; Martin, G. Effect of medium osmolarity on the bioproduction of glycerol and ethanol by Hansenula anomala growing on glucose and ammonium. Appl. Microbiol. Biotechnol. 2005, 69, 341–349. [Google Scholar] [CrossRef] [PubMed]
- Schindler, B.D. Understanding and Improving Respiratory Succinate Production from Glycerol by Actinobacillus succinogenes. Ph.D. Thesis, Michigan State University, East Lansing, MI, USA, 2011. [Google Scholar]
- Salma, A.; Abdallah, R.; Fourcade, F.; Amrane, A.; Djelal, H. A new approach to produce succinic acid through a co-culture system. Appl. Biochem. Biotechnol. 2021, 1–21. [Google Scholar] [CrossRef]
- Wang, Z.; Xiao, W.; Zhang, A.; Ying, H.; Chen, K.; Ouyang, P. Potential industrial application of Actinobacillus succinogenes NJ113 for pyruvic acid production by microaerobic fermentation. Korean J. Chem. Eng. 2016, 33, 2908–2914. [Google Scholar] [CrossRef]
- Pateraki, C.; Patsalou, M.; Vlysidis, A.; Kopsahelis, N.; Webb, C.; Koutinas, A.A.; Koutinas, M. Actinobacillus succinogenes: Advances on succinic acid production and prospects for development of integrated biorefineries. Biochem. Eng. J. 2016, 112, 285–303. [Google Scholar] [CrossRef]
- Zou, W.; Zhu, L.-W.; Li, H.-M.; Tang, Y.-J. Significance of CO2 donor on the production of succinic acid by Actinobacillus succinogenes ATCC 55618. Microb. Cell Factories 2011, 10, 87. [Google Scholar] [CrossRef]
- Vaswani, S. Bio-Based Succinic Acid; SRI Consulting: Marco Island, FL, USA, 2010. [Google Scholar]
- Olajuyin, A.M.; Yang, M.; Thygesen, A.; Tian, J.; Mu, T.; Xing, J. Effective production of succinic acid from coconut water (Cocos nucifera) by metabolically engineered Escherichia coli with overexpression of Bacillus subtilis pyruvate carboxylase. Biotechnol. Rep. 2019, 24, e00378. [Google Scholar] [CrossRef]
- Jampatesh, S.; Sawisit, A.; Wong, N.; Jantama, S.S.; Jantama, K. Evaluation of inhibitory effect and feasible utilization of dilute acid-pretreated rice straws on succinate production by metabolically engineered Escherichia coli AS1600a. Bioresour. Technol. 2019, 273, 93–102. [Google Scholar] [CrossRef]
- Sawisit, A.; Jampatesh, S.; Jantama, S.S.; Jantama, K. Optimization of sodium hydroxide pretreatment and enzyme loading for efficient hydrolysis of rice straw to improve succinate production by metabolically engineered Escherichia coli KJ122 under simultaneous saccharification and fermentation. Bioresour. Technol. 2018, 260, 348–356. [Google Scholar] [CrossRef]
- Sahoo, K.; Sahoo, R.K.; Gaur, M.; Subudhi, E. Cellulolytic thermophilic microorganisms in white biotechnology: A review. Folia Microbiol. 2019, 65, 25–43. [Google Scholar] [CrossRef]
- Singh, R.S.; Singhania, R.R.; Pandey, A.; Larroche, C. Biomass, Biofuels, Biochemicals: Advances in Enzyme Technology; Elsevier: Amsterdam, The Netherlands, 2019. [Google Scholar]
- Fernie, A.R.; Zhang, Y.; Sweetlove, L.J. Passing the baton: Substrate channelling in respiratory metabolism. Research 2018, 2018, 1–16. [Google Scholar] [CrossRef] [PubMed]
- Sakihama, Y.; Hidese, R.; Hasunuma, T.; Kondo, A. Increased flux in acetyl-CoA synthetic pathway and TCA cycle of Kluyveromyces marxianus under respiratory conditions. Sci. Rep. 2019, 9, 1–10. [Google Scholar] [CrossRef] [PubMed]
- Ahn, J.H.; Jang, Y.-S.; Lee, S.Y. Production of succinic acid by metabolically engineered microorganisms. Curr. Opin. Biotechnol. 2016, 42, 54–66. [Google Scholar] [CrossRef] [PubMed]
- Meng, J.; Wang, B.; Liu, D.; Chen, T.; Wang, Z.; Zhao, X. High-yield anaerobic succinate production by strategically regulating multiple metabolic pathways based on stoichiometric maximum in Escherichia coli. Microb. Cell Factories 2016, 15, 1–13. [Google Scholar] [CrossRef] [PubMed]
- Dessie, W.; Zhang, W.; Xin, F.; Dong, W.; Zhang, M.; Ma, J.; Jiang, M. Succinic acid production from fruit and vegetable wastes hydrolyzed by on-site enzyme mixtures through solid state fermentation. Bioresour. Technol. 2018, 247, 1177–1180. [Google Scholar] [CrossRef]
- Thakker, C.; San, K.-Y.; Bennett, G.N. Production of succinic acid by engineered E. coli strains using soybean carbohydrates as feedstock under aerobic fermentation conditions. Bioresour. Technol. 2013, 130, 398–405. [Google Scholar] [CrossRef]
- Widiastuti, H.; Lee, N.-R.; Karimi, I.A.; Lee, D.-Y. Genome-scale in silico analysis for enhanced production of succinic Acid in Zymomonas mobilis. Processes 2018, 6, 30. [Google Scholar] [CrossRef]
- McKinlay, J.B.; Shachar-Hill, Y.; Zeikus, J.G.; Vieille, C. Determining Actinobacillus succinogenes metabolic pathways and fluxes by NMR and GC-MS analyses of 13C-labeled metabolic product isotopomers. Metab. Eng. 2007, 9, 177–192. [Google Scholar] [CrossRef]
- Urbance, S.E.; Pometto, A.; Dispirito, A.; Denli, Y. Evaluation of succinic acid continuous and repeat-batch biofilm fermentation by Actinobacillus succinogenes using plastic composite support bioreactors. Appl. Microbiol. Biotechnol. 2004, 65, 664–670. [Google Scholar] [CrossRef]
- Van Heerden, C.; Nicol, W. Continuous succinic acid fermentation by Actinobacillus succinogenes. Biochem. Eng. J. 2013, 73, 5–11. [Google Scholar] [CrossRef]
- Kim, N.J.; Chang, Y.K.; Lee, S.Y.; Kim, M.I.; Kim, N.J.; Shang, L. Continuous production of succinic acid using an external membrane cell recycle system. J. Microbiol. Biotechnol. 2009, 19, 1369–1373. [Google Scholar] [CrossRef]
- Guettler, M.V.; Jain, M.K.; Rumler, D. Method for Making Succinic Acid, Bacterial Variants for Use in the Process, and Methods for Obtaining Variants. U.S. Patent No 5,573,931, 12 November 1996. [Google Scholar]
- Villadsen, J.; Nielsen, J.; Lidén, G. Bioreaction Engineering Principles, 3rd ed.; Springer: New York, NY, USA, 2011. [Google Scholar]
- Van Heerden, C.D.; Nicol, W. Continuous and batch cultures of Escherichia coli KJ134 for succinic acid fermentation: Metabolic flux distributions and production characteristics. Microb. Cell Factories 2013, 12, 80. [Google Scholar] [CrossRef]
- McKinlay, J.B.; Zeikus, J.G.; Vieille, C. Insights into Actinobacillus succinogenes fermentative metabolism in a chemically defined growth medium. Appl. Environ. Microbiol. 2005, 71, 6651–6656. [Google Scholar] [CrossRef] [PubMed]
- Rühl, M.; Le Coq, D.; Aymerich, S.; Sauer, U. 13C-flux analysis reveals NADPH-balancing transhydrogenation cycles in stationary phase of nitrogen-starving Bacillus subtilis. J. Biol. Chem. 2012, 287, 27959–27970. [Google Scholar] [CrossRef] [PubMed]
- Corona-González, R.I.; Bories, A.; González-Álvarez, V.; Pelayo-Ortiz, C. Kinetic study of succinic acid production by Actinobacillus succinogenes ZT-130. Process. Biochem. 2008, 43, 1047–1053. [Google Scholar] [CrossRef]
- Liu, Y.-P.; Zheng, P.; Sun, Z.-H.; Ni, Y.; Dong, J.-J.; Zhu, L.-L. Economical succinic acid production from cane molasses by Actinobacillus succinogenes. Bioresour. Technol. 2008, 99, 1736–1742. [Google Scholar] [CrossRef] [PubMed]
- Chitra, M.; Pappa, N.; Abraham, A. Dissolved oxygen control of batch bioreactor using model reference adaptive control scheme. IFAC PapersOnLine 2018, 51, 13–18. [Google Scholar] [CrossRef]
- Rhie, M.N.; Park, B.; Ko, H.; Choi, I.; Bin Kim, O. Transcriptome analysis and anaerobic C4-dicarboxylate transport in Actinobacillus succinogenes. MicrobiologyOpen 2017, 7, e00565. [Google Scholar] [CrossRef] [PubMed]
- Rhie, M.N.; Yoon, H.E.; Oh, H.Y.; Zedler, S.; Unden, G.; Bin Kim, O. A Na+-coupled C4-dicarboxylate transporter (Asuc_0304) and aerobic growth of Actinobacillus succinogenes on C4-dicarboxylates. Microbiology 2014, 160, 1533–1544. [Google Scholar] [CrossRef]
- Hellingwerf, K.J.; Mattos, M.J.T.D. Process for Producing an Organic Compound. U.S. Patent No. 9,228,210, 1 May 2019. [Google Scholar]
- Lin, S.K.C.; Du, C.; Koutinas, A.; Wang, R.; Webb, C. Substrate and product inhibition kinetics in succinic acid production by Actinobacillus succinogenes. Biochem. Eng. J. 2008, 41, 128–135. [Google Scholar] [CrossRef]
- Jiang, M.; Dai, W.; Xi, Y.; Wu, M.; Kong, X.; Ma, J.; Zhang, M.; Chen, K.; Wei, P. Succinic acid production from sucrose by Actinobacillus succinogenes NJ113. Bioresour. Technol. 2014, 153, 327–332. [Google Scholar] [CrossRef] [PubMed]
- Alexandri, M.; Vlysidis, A.; Papapostolou, H.; Tverezovskaya, O.; Tverezovskiy, V.; Kookos, I.; Koutinas, A. Downstream separation and purification of succinic acid from fermentation broths using spent sulphite liquor as feedstock. Sep. Purif. Technol. 2019, 209, 666–675. [Google Scholar] [CrossRef]
- Bradfield, M.F.A.; Mohagheghi, A.; Salvachúa, D.; Smith, H.W.; Black, B.A.; Dowe, N.; Beckham, G.T.; Nicol, W. Continuous succinic acid production by Actinobacillus succinogenes on xylose-enriched hydrolysate. Biotechnol. Biofuels 2015, 8, 1–17. [Google Scholar] [CrossRef] [PubMed]
- Liu, Y.-P.; Zheng, P.; Sun, Z.-H.; Ni, Y.; Dong, J.-J.; Wei, P. Strategies of pH control and glucose-fed batch fermentation for production of succinic acid by Actinobacillus succinogenes CGMCC1593. J. Chem. Technol. Biotechnol. 2008, 83, 722–729. [Google Scholar] [CrossRef]
- Lee, S.J.; Song, H. Genome-based metabolic engineering of Mannheimia succiniciproducens for succinic acid production. Appl. Environ. Microbiol. 2006, 72, 1939–1948. [Google Scholar] [CrossRef]
- Thuy, N.T.H.; Kongkaew, A.; Flood, A.; Boontawan, A. Fermentation and crystallization of succinic acid from Actinobacillus succinogenes ATCC55618 using fresh cassava root as the main substrate. Bioresour. Technol. 2017, 233, 342–352. [Google Scholar] [CrossRef]
- Louasté, B.; Eloutassi, N. Succinic acid production from whey and lactose by Actinobacillus succinogenes 130Z in batch fermentation. Biotechnol. Rep. 2020, 27, e00481. [Google Scholar] [CrossRef]
- Lo, E.; Brabo-Catala, L.; Dogaris, I.; Ammar, E.; Philippidis, G.P. Biochemical conversion of sweet sorghum bagasse to succinic acid. J. Biosci. Bioeng. 2020, 129, 104–109. [Google Scholar] [CrossRef]
- Chen, K.-Q.; Li, J.; Ma, J.-F.; Jiang, M.; Wei, P.; Liu, Z.-M.; Ying, H.-J. Succinic acid production by Actinobacillus succinogenes using hydrolysates of spent yeast cells and corn fiber. Bioresour. Technol. 2011, 102, 1704–1708. [Google Scholar] [CrossRef]
- Zheng, P.; Fang, L.; Xu, Y.; Dong, J.-J.; Ni, Y.; Sun, Z.-H. Succinic acid production from corn stover by simultaneous saccharification and fermentation using Actinobacillus succinogenes. Bioresour. Technol. 2010, 101, 7889–7894. [Google Scholar] [CrossRef] [PubMed]
- Mokwatlo, S.C.; Nchabeleng, M.E.; Brink, H.G.; Nicol, W. Impact of metabolite accumulation on the structure, viability and development of succinic acid–producing biofilms of Actinobacillus succinogenes. Appl. Microbiol. Biotechnol. 2019, 103, 6205–6215. [Google Scholar] [CrossRef] [PubMed]
- Corona-González, R.I.; Bories, A.; González-Álvarez, V.; Snell-Castro, R.; Toriz-González, G.; Pelayo-Ortiz, C. Succinic acid production with Actinobacillus succinogenes ZT-130 in the presence of succinic acid. Curr. Microbiol. 2009, 60, 71–77. [Google Scholar] [CrossRef]
- Maharaj, K.; Bradfield, M.F.A.; Nicol, W. Succinic acid-producing biofilms of Actinobacillus succinogenes: Reproducibility, stability and productivity. Appl. Microbiol. Biotechnol. 2014, 98, 7379–7386. [Google Scholar] [CrossRef] [PubMed][Green Version]
- Othman, M.; Ariff, A.B.; Wasoh, H.; Kapri, M.R.; Halim, M. Strategies for improving production performance of probiotic Pediococcus acidilactici viable cell by overcoming lactic acid inhibition. AMB Express 2017, 7, 1–14. [Google Scholar] [CrossRef] [PubMed]

| Initial Sugar Concentration (mol L−1) | Consumed Sugar (%) | SA (mol L−1) | Aλ660 nm | Yield (molC/molC) | Productivity (g L−1 h−1) | ||||||
|---|---|---|---|---|---|---|---|---|---|---|---|
| A | B | A | B | A | B | A | B | A | B | A | B |
| 0.05 | 0.04 | 91.90 | 99.70 | 0.04 | 0.025 | 0.13 | 0.17 | 0.90 | 0.67 | 0.33 | 0.06 |
| 0.19 | 0.13 | 87.24 | 92.44 | 0.14 | 0.07 | 0.41 | 0.18 | 0.94 | 0.59 | 0.39 | 0.17 |
| 0.26 | 0.15 | 88.05 | 83.44 | 0.09 | 0.11 | 0.49 | 0.38 | 0.40 | 0.89 | 0.22 | 0.27 |
| Runs | 0 | 1 | 2 | 3 | 4 | 5 |
|---|---|---|---|---|---|---|
| FA (mol L−1) | 0 | 0.0008 | 0.0017 | 0.0025 | 0.0034 | 0.0042 |
| OD660 nm | 0.28 | 0.25 | 0.24 | 0.23 | 0.18 | 0.13 |
| Consumed glucose (%) | 97.54 | 97.99 | 97.94 | 83.81 | 86.74 | 95.76 |
| Consumed fructose (%) | 97.04 | 97.60 | 97.60 | 93.83 | 92.94 | 94.41 |
| SA (mol L−1) | 0.18 | 0.22 | 0.22 | 0.23 | 0.23 | 0.23 |
| pH | 6.00 | 5.98 | 5.65 | 5.53 | 5.66 | 5.32 |
| Yield (mol-C/mol-C) | 0.47 | 0.57 | 0.57 | 0.66 | 0.56 | 0.62 |
| Productivity (g L−1 h−1) | 0.17 | 0.21 | 0.21 | 0.22 | 0.22 | 0.22 |
| Relative (%) | 0 | 18.9 | 22.1 | 25.9 | 27.56 | 28.0 |
| Runs | 1 | 2 | 3 |
|---|---|---|---|
| Glucose concentration (mol L−1) | 0.2 | - | - |
| Consumed glucose (%) | 97.14 | - | - |
| Fructose concentration (mol L−1) | 0.2 | - | - |
| Consumed fructose (%) | 97.01 | - | - |
| FA (mol L−1) | 0.087 | 0.043 | 0.087 |
| Consumed FA (%) | 100 | 100 | 100 |
| SA (mol L−1) | 0.492 | 0.037 | 0.083 |
| Yield * | 0.99 | 0.88 | 0.91 |
| Productivity (g L−1 h−1) | 0.48 | 0.036 | 0.081 |
| Conversion yield (%) | 61.87 | 86.04 | 95.4 |
| Runs | 1 | 2 | 3 | 4 | 5 |
|---|---|---|---|---|---|
| Glucose concentration (mol L−1) | 0.05 | 0.05 | 0.05 | - | - |
| Consumed glucose (%) | 99.05 | 98.87 | 96.67 | - | - |
| Fructose concentration (mol L−1) | 0.05 | 0.05 | 0.05 | - | - |
| Consumed fructose (%) | 97.62 | 98.09 | 96.72 | - | - |
| FA (mol L−1) | - | 0.1 | 0.2 | 0.1 | 0.2 |
| Consumed FA (%) | - | 92.55 | 96.16 | 99.33 | 98.92 |
| SA (mol L−1) | 0.053 | 0.17 | 0.24 | 0.09 | 0.15 |
| Extra SA (mol L−1) | 0 | 0.11 | 0.187 | - | - |
| Yield * | 0.58 | 0.92 | 0.85 | 0.94 | 0.74 |
| Productivity (g L−1 h−1) | 0.05 | 0.18 | 0.25 | 0.09 | 0.16 |
| Conversion yield (%) | 54.63 | 89.47 | 85.71 | 100 | 76.14 |
| % of difference (absolute value) | - | 27 | 2.6 | 0 | 24 |
| Runs | 1 | 2 | 3 | 4 | 5 | ||
|---|---|---|---|---|---|---|---|
| Fermentation time (h) | 104 | 48 | 48 | 48 | 96 | 120 | 96 |
| Glucose concentration (mol L−1) | 0.05 | 0.2 | 0.26 | - | 0.1 | 0.2 | - |
| Fructose concentration (mol L−1) | - | - | - | 0.15 | 0.1 | 0.2 | - |
| Fumarate concentration (mol L−1) | - | - | - | - | - | 0.087 | 0.2 |
| dS/dt (g L−1 h−1) | 0.06 | 0.64 | 0.86 | 0.48 | 0.34 | 0.66 | 0.23 |
| dP/dt (g L−1 h−1) | 0.01 | 0.34 | 0.24 | 0.29 | 0.27 | 0.48 | 0.18 |
| Yp/s | 16.4 | 54.1 | 28.5 | 60.7 | 79.4 | 72.8 | 77.8 |
| Yx/s | ≈0 | 1.69 | 1.3 | 2.2 | 2.7 | 1.47 | 1.00 |
| Yp/x | - | 31.8 | 21.5 | 26.8 | 130.2 | 49.10 | 89.8 |
| % closure of mass balance | 16.4 | 55.7 | 29.8 | 62.9 | 82.1 | 74.2 | 78.8 |
| Yield (mol-SA/g-DCW) | - | 0.26 | 0.18 | 0.22 | 0.25 | 0.41 | 0.65 |
| (SA) ratio (o/t) | 14.7 | 48.2 | 25.6 | 54.5 | 71.0 | 65.3 | 76.1 |
| Runs | Controlled pH | Non-Controlled pH |
|---|---|---|
| Total sugars concentration (mol L−1) | 0.4 | 0.4 |
| Consumed glucose (%) | 96.83 | 93.30 |
| Consumed fructose (%) | 98.26 | 91.39 |
| Consumed fumarate (%) | 96.49 | 96.07 |
| dP/dt (g L−1 h−1) | 0.50 | 0.49 |
| Yp/s (mol-C/mol-C) | 0.88 | 0.87 |
| SA (mol L−1) | 0.41 | 0.40 |
| Volume (mL) | 250 | 1000 | 3000 |
|---|---|---|---|
| Working volume (mL) | 200 | 800 | 1800 |
| SA (mol L−1) | 0.40 | 0.28 | 0.41 |
| dP/dt (g L−1 h−1) | 0.49 | 0.26 | 0.50 |
| Yp/s (mol-C/mol-C) | 0.81 | 0.57 | 0.88 |
| Micro-Organisms | Substrate | Fermentation Strategy | Succinic Acid Production | Ref. | ||
|---|---|---|---|---|---|---|
| Concentration | Yield | Productivity | ||||
| A. succinogenes CGMCC1593 | Glucose | Batch | 0.32 | 1.25 | 1.00 | [56,65] |
| Fed-batch | 0.50 | 1.2 | 1.30 | |||
| M. succinio-producens LPK7 | Glucose | Batch | 0.11 | 0.97 | 1.22 | [66] |
| Fed-batch | 0.44 | 1.16 | 1.80 | |||
| A. succinogenes DSMZ 22257 | Glucose, Fructose | Batch | 0.50 | 0.88 | 0.48 | This study |
| A. Succinogenes 130 Z | whey | Batch | 0.11 | 1.67 | 0.61 | [68] |
| A. succinogenes NJ113 | Sweetsorghum bagasse | Batch | 0.15 | 0.93 | 0.98 | [69] |
| A. succinogenes 130 Z | Rapeseed meal | Batch | 0.13 | 0.20 | 0.22 | [70] |
| Fed-batch | 0.19 | 0.20 | 0.33 | |||
| A.succinogenes 130 Z | Raw carob pods | Batch | 0.07 | 0.55 | 1.32 | [24] |
| A. succinogenes ATCC55618 | Cassava roots | Batch | 0.78 | 1.3 | 1.87 | [67] |
| Fed-batch | 1.27 | 2.4 | 3.22 | |||
| A. succinogenes CGMCC1593 | Corn straw | Batch | 0.38 | 1.36 | 0.95 | [71] |
| Fed-batch | 0.44 | 1.4 | 1.21 | |||
Publisher’s Note: MDPI stays neutral with regard to jurisdictional claims in published maps and institutional affiliations. |
© 2021 by the authors. Licensee MDPI, Basel, Switzerland. This article is an open access article distributed under the terms and conditions of the Creative Commons Attribution (CC BY) license (https://creativecommons.org/licenses/by/4.0/).
Share and Cite
Salma, A.; Djelal, H.; Abdallah, R.; Fourcade, F.; Amrane, A. Well Knowledge of the Physiology of Actinobacillus succinogenes to Improve Succinic Acid Production. Appl. Microbiol. 2021, 1, 304-328. https://doi.org/10.3390/applmicrobiol1020022
Salma A, Djelal H, Abdallah R, Fourcade F, Amrane A. Well Knowledge of the Physiology of Actinobacillus succinogenes to Improve Succinic Acid Production. Applied Microbiology. 2021; 1(2):304-328. https://doi.org/10.3390/applmicrobiol1020022
Chicago/Turabian StyleSalma, Alaa, Hayet Djelal, Rawa Abdallah, Florence Fourcade, and Abdeltif Amrane. 2021. "Well Knowledge of the Physiology of Actinobacillus succinogenes to Improve Succinic Acid Production" Applied Microbiology 1, no. 2: 304-328. https://doi.org/10.3390/applmicrobiol1020022
APA StyleSalma, A., Djelal, H., Abdallah, R., Fourcade, F., & Amrane, A. (2021). Well Knowledge of the Physiology of Actinobacillus succinogenes to Improve Succinic Acid Production. Applied Microbiology, 1(2), 304-328. https://doi.org/10.3390/applmicrobiol1020022

